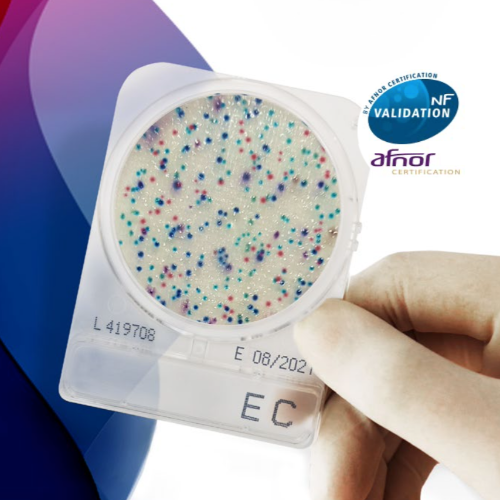
CompactDry certified by Afnor

CompactDry certified by Afnor
Product
Information
CompactDry range of ready-to-use culture media has recently obtained AFNOR certification.
Obtaining AFNOR certification is a major asset, reinforcing the confidence of laboratories
in the products and its method of use. This certification demonstrates the excellence of the product and the
robustness of the method, guaranteeing:
• Regular independent controls ensuring quality
• Official recognition reinforcing its credibility on the market
• Full traceability and reliability of results
• Compliance with regulatory requirements and standards in force
• Specific validation for laboratories, ensuring the reliability and comparability of analyses
The company Shimadzu Diagnostics Europe, manufacturer of the range of ready-to-use culture media –
Compact Dry, has recently obtained AFNOR certification. The Compact Dry are distributed within
Humeau.
Humeau Expert du laboratoire is very pleased to offer the Compact Dry range among its products. Combining ease of use and compliance with the highest quality standards on the market, this ready-to-use chromogenic system enables the detection and quantification of microorganisms in raw materials and finished products.
Brand
Shimadzu
Sectors
Equipment & Processes
Application markets
Cereals/ Grains/ Starchy products
Regions
All